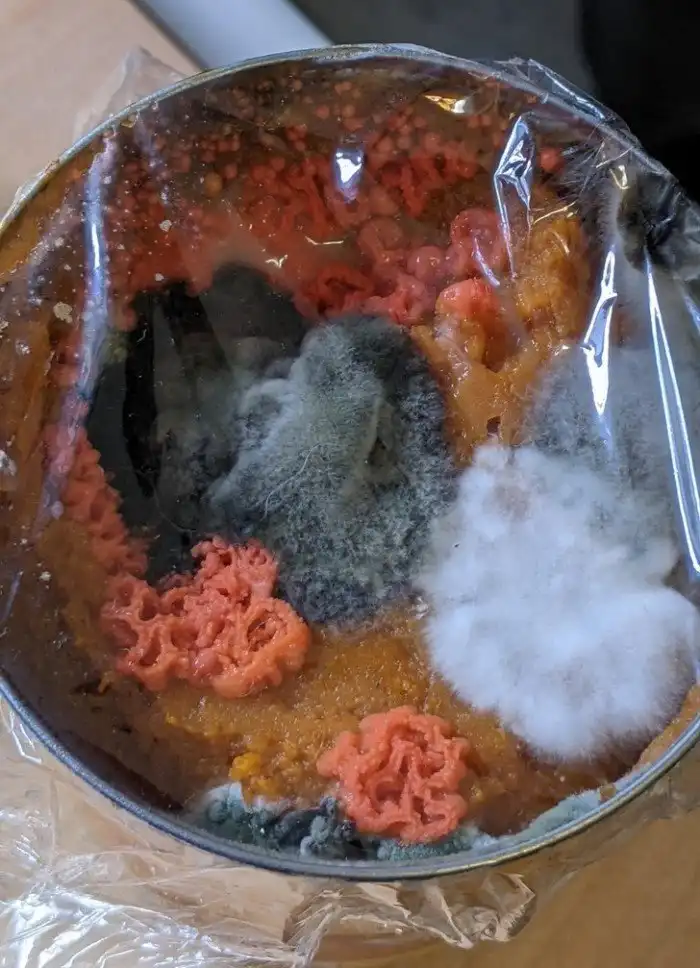

30+ людей, которые обнаружили кое-что интересное
Такие штуки не каждый день попадаются на глаза!
«В пакетике с сушеными кусочками кальмара мне попался один целый»

"Никогда не обращала внимания, что у тени от очков линзы затенены"

«Я думала, что это красивый камень, а оказалось, что это мыло»

"Машина-сад стоит на одной из центральных улиц Торонто"

"Мы попросили дополнительные соусы - и нам дали три полных мешка!"

«Это надгробие делят сестры-близнецы: одна прожила всего два дня, другая — 101 год»

«Это дерево проросло на табличку и под краску»

"Сегодня я получила эту долларовую купюру с браком печати в качестве чаевых»

"Заказал один соус ранч, заплатил за один, а привезли десять"

«Бабушка моей подруги использует свой старый телевизор как подставку для плазменного телевизора»

«Вместо балкона в моем гостиничном номере был собственный внутренний дворик»

«Наш робот-пылесос царапал кофейный столик, поэтому моя девушка связала ему носки»

«Вот как вырос мой друг, мышонок Пит, за последние три недели»

«При осмотре дома выяснилось, что в туалет заливается горячая вода, об этом рассказало инфракрасное изображение»

"Кажется, на каменной плитке у меня в ванной - древняя раковина наутилуса"

«В моем отеле в Стамбуле на завтрак подавали целые рамки с сотами»

Так выглядят 100 долларов 1934 года по сравнению с современными

«Я сделал маленький нож из бутылки из-под джина Bombay и куска рога»

«Осадок на дне моей кофейной чашки похож на сосновый лес»

"Я купила эту старую книгу с рук - и нашла в ней билет на игры Олимпиады-2000 в Сиднее"

Так выглядит фестиваль Burning Man с высоты птичьего полета"

«В этом баре есть охлаждающая полоса, на которой напитки долго остаются холодными».

"Опоздала на работу из-за внепланового парада"

"Под моей машиной сидит пингвин и не хочет уходить"

"В моем яйце оказалось еще одно яйцо"

"Паук починил порванную сетку на дачной двери"

«В забытой банке тыквенного пюре через пару месяцев появились бактериальные культуры»
«На этом светофоре в Германии сигнальные огни сделаны в форме маленькой девочки с верблюдом»

Белка-меланист

"Для доставки моего велосипеда компания-доставщик использовала коробку из-под аквариума, чтобы не привлекать воришек. Но велосипед на ней тодже нарисован"

"Завалившаяся под кухонный диван и проросшая там картошка стала похожа на монстра"

